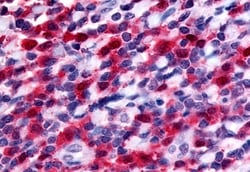

Learn More
Invitrogen™ FLT3 Polyclonal Antibody


Description
Percent identity with other species by BLAST analysis: Human, Gorilla, Gibbon, Monkey (100%); Marmoset, Rabbit (95%); Hamster (85%); Bovine, Dog, Panda, Horse (80%). For IHC(P), use heat induced antigen retrieval in pH 6.0 citrate buffer. After incubation with the primary antibody, slides were incubated with biotinylated secondary antibody, followed by alkaline phosphatase-streptavidin and chromogen.

Specifications
Specifications
| Antigen | FLT3 |
| Applications | ELISA, Immunohistochemistry (Paraffin) |
| Classification | Polyclonal |
| Concentration | 1 mg/mL |
| Conjugate | Unconjugated |
| Formulation | PBS with 0.1% sodium azide |
| Gene | FLT3 |
| Gene Accession No. | P36888 |
| Gene Alias | B230315G04; CD135; CD135 antigen; fetal liver kinase 2; Fetal liver kinase-2; FL cytokine receptor; FLK2; Flk-2; FLT3; Flt-3; fms related tyrosine kinase 3; FMS-like tyrosine kinase 3; fms-related tyrosine kinase 3; growth factor receptor tyrosine kinase type III; Ly72; OTTHUMP00000214829; Receptor-type tyrosine-protein kinase FLT3; RP11-153M24.3; stem cell tyrosine kinase 1; STK1; STK-1; tyrosine-protein kinase FLT3; tyrosine-protein kinase receptor flk-2; wmfl |
| Gene Symbols | FLT3 |
| Show More |
By clicking Submit, you acknowledge that you may be contacted by Fisher Scientific in regards to the feedback you have provided in this form. We will not share your information for any other purposes. All contact information provided shall also be maintained in accordance with our Privacy Policy.